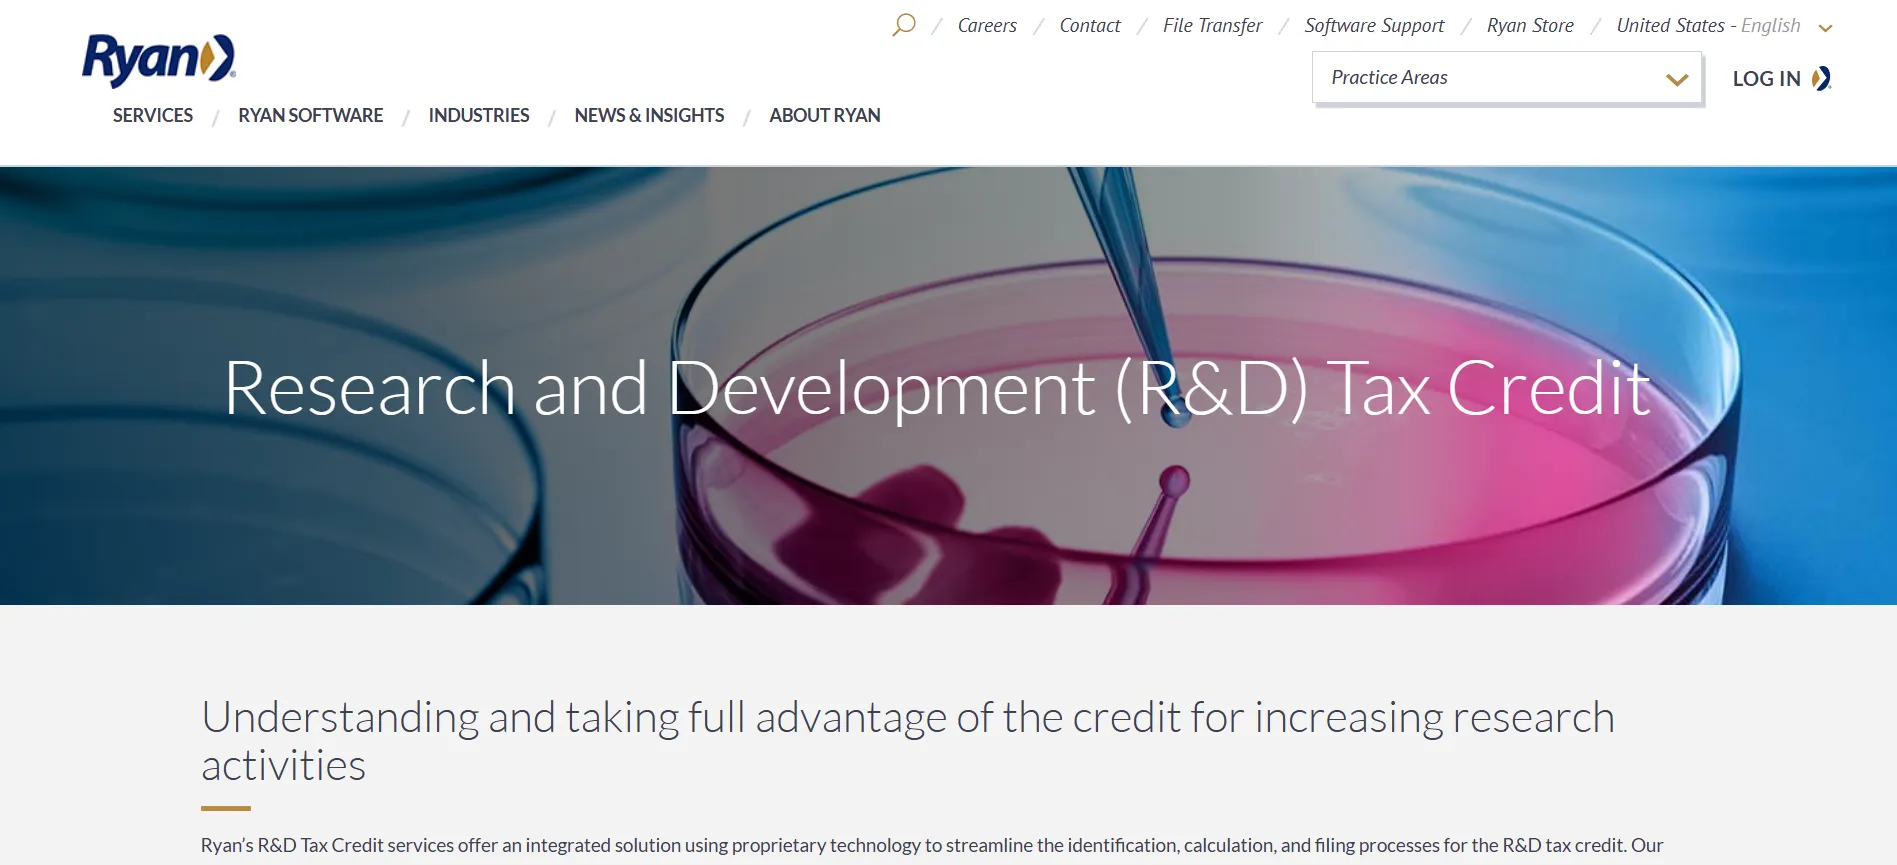
Ryan highlighting its research and development tax credit solutions.

Compare top R&D tax credit consultants and maximize your SME claim.

R&D tax credit applications can turn into guesswork when your data sits in scattered tools, your engineers shift between roles, and Section 174 rules raise the stakes. To avoid all of this, you need partners who understand how modern teams operate and who can work fast with clean inputs.
In this guide, you’ll see how top consultants differ and how a tool like Chrono Platform strengthens your SME R&D tax credit process.
But first, let’s set the ground with a clear look at the credit itself.
Note: This list isn’t exhaustive because we’re actively forming new partnerships. If you want to collaborate with us, you can visit our partnerships page.
The SME R&D tax credit is a federal incentive that lets you offset part of your qualified research expenses and turn engineering work into meaningful tax relief. The credit gives you financial room to keep shipping, hiring, and running experiments even when cash flow is tight.
This usually includes wages tied to technical problem-solving, as well as:
That said, the impact depends on how well you track and categorize the work.
Section 174 used to create real cash-flow pressure. From 2022 through 2024, companies were forced to amortize their research costs over five years instead of taking an immediate deduction.
That rule has since changed: domestic R&E is once again eligible for full expensing, while foreign research must still be amortized over fifteen years.
This broader push to strengthen research incentives has also been recognized at the policy level. The SBE Council noted, referencing the “One Big Beautiful Bill”:
“This provision represents an immediate and significant cash stimulus for those businesses that qualify for this R&D tax incentive, and positively impacts the entirety of our constituencies. … The policy goal is to encourage greater investment that will lead to more innovation across industry sectors.”
Even with that relief, the rules now require clearer activity mapping and tighter documentation, because the IRS still expects precise categorization of research costs.
Because of that, your R&D tax credit claim depends on consistent data across Jira, calendars, and engineering notes.
And that’s where the right support helps you move with confidence.
That brings us to the next point.
Research published by the American Economic Association shows that eligible firms increased R&D spending by about 17% after using the credit. And smaller companies with cash-flow pressure benefited the most.
This tells us that a precise claim changes your ability to invest in engineering work.
Hiring an R&D tax credit consultant helps you shape that strong R&D tax credit SME claim because they handle the technical, financial, and compliance steps.
After all, your team already works across shifting priorities, mixed engineering roles, and limited time for detailed documentation.
When those factors collide, your claim quality drops.
A consultant helps you focus on higher-value work while they handle the R&D approval tasks that slow you down. Since clean inputs drive better outcomes, these are the benefits you gain:
Pro tip: One amazing tool supports this entire process, and you can read about it below.
We all know that your data rarely sits in one place.
Jira boards mix shipping tickets with exploratory work. Slack threads hide decisions. Calendar events lack technical context, and so on…
So, this is where Chrono Platform steps in.
Chrono Platform is an AI-powered platform that turns scattered engineering activity into clear inputs for R&D tax credit claims. That’s especially useful for SME teams, though enterprise teams benefit as well.
The platform categorizes tasks, connects them to qualifying activities, and reverse-categorizes older work when tax laws shift. That level of structure removes the guesswork that normally slows your claims.

Even with domestic R&E returning to immediate expensing, Section 174 still affects the timing of foreign R&E deductions and increases the need for precise narrative clarity.
That’s something Chrono Platform handles automatically so you can avoid misclassification and budget surprises. You also gain a year-round record that removes any issues at filing time.
Chrono Platform also gives your consultants a clean foundation. Instead of sending screenshots, mixed spreadsheets, or half-completed time logs, you hand over structured data tied to your engineering workflow.
Even better, you can give your consultants access to your account so they can get this data from Chrono themselves.
That reduces their review time and lowers costs for you. It also gives them the context they need to defend your claim during an audit, since they can trace each technical activity back to factual records rather than broad summaries.

Empego used Chrono Platform to map engineering work in real time and cut down the hours spent preparing technical explanations.
That clarity helped the company track qualifying activity without slowing down its shipping pace. It also improved collaboration between its finance and engineering teams, since everyone could see which tasks supported the credit.
Besides, using our platform got them other good results, starting with over $450,000 in savings.

Now, let’s review the consultants who frequently support this type of workflow.
The best R&D tax credit consultants for SMEs are Massie Tax Credits, Momentum Tax Group, Cherry Bekaert, Ryan’s R&D Tax Credit, and several others.
As we mentioned before, this isn’t a complete list, as we’re continuing to form new partnerships. If you want to collaborate with us, you can visit our partnerships page.

Massie Tax Credits has created a process built around your technical teams rather than generic tax workflows.
Its MASSIE Method focuses on conversations with engineers, hands-on project reviews, and clear documentation binders that simplify audits. This matters when your claim depends on activity-level detail and clean wage allocation.
The company’s team interviews people across departments and sorts the information into structured files that help you defend your position later. Also, it aims to reduce noise for your engineers by keeping participation simple while still capturing usable evidence.
A client from Arris International noted higher credit values and lower effort after switching to Massie. This shows how process design shapes outcomes under tightening SME R&D tax credit rates.

Momentum Tax Group stands out through its technical range and its skilled observation approach. Instead of relying only on interviews, the team studies your projects directly, which helps them capture qualifying work that might appear routine on paper.
This approach can support your company if you work with complex engineering setups or physical prototypes.
The firm’s five-step method combines observation, financial validation, and detailed reports aligned with HMRC standards. And since this team includes a former HMRC inspector, you gain insight into how reviewers interpret evidence during compliance checks.
For example, a Glasgow engineering firm used this process to document deep-water submersible work and secure meaningful credit value. So, this level of analysis matters when you face mixed activity across engineering, operations, and support under a fixed SME R&D tax credit cap.

Cherry Bekaert offers a structured, data-heavy process built for companies with larger teams or multiple parallel projects. This platform, powered by Kipsi, helps companies sort financial records, interview notes, and technical documentation into audit-ready reports. That gives you a clear picture of qualifying activity and reduces gaps when rules shift.
Also, this is where Chrono Platform can help you move faster.
When you share structured activity records and categorized tasks from our platform, Cherry’s team can run studies with fewer follow-up questions and far less manual clean-up.
You can see the impact of this approach in how one of Cherry’s clients in environmental engineering gained nearly $400,000 in R&D credits through detailed time analysis and clear wage mapping.

Ryan gives you tax depth if you have multi-entity or cross-border operations, but need clear guidance as an SME. With more than 6,500 professionals serving 77,000 clients in 80+ countries, this company brings scale and repeatable process to complex claims.
The team maps projects to the four-part test, quantifies QREs, and chooses between RRC and ASC based on what yields the strongest position. When your records are messy, this team also uses IRS-approved estimation methods, which matters if time tracking is weak.
Again, this is where Chrono Platform can help. Structured engineering data from Chrono Platform shortens their analysis time and improves traceability between technical work and QRE calculations.
That clarity makes it easier for your tax advisors to support QSB payroll offset elections and ESB AMT relief. Now, they can rely on consistent, project-level activity records rather than fragmented documentation.
Tri-Merit focuses on specialty tax work through CPAs, so you gain a partner that already understands your existing advisory setup. Its team of CPAs, engineers, and attorneys treats the R&D credit as an engineering problem first, then a tax calculation. That combination lets them spot missed expenses, choose better calculation methods, and clean up methodology risks.
The company’s automotive remanufacturer case shows the impact. Credits rose from under $75,000 to about $350,000 in year one and nearly $500,000 annually after process changes. Tri-Merit also corrected supply-cost errors that had raised audit risk.
So you get higher claims supported by better documentation, without forcing your teams into constant manual hour tracking. That balance works well for busy SME leadership teams.

Ayming USA gives you global experience with a focus on speed and minimal disruption. With more than 35 years in innovation incentives and over $2 billion secured for clients in five years, this company is comfortable handling multi-entity manufacturing, software, and biotech work.
Its four-phase model moves from no-cost eligibility review to full audit support, which helps if you want to test the opportunity before committing. Also, Ayming’s rapid claims service is a clear draw where studies finish in 14-21 days instead of the 45-60 day industry norm.
The Armoured One case shows how this plays out by turning security manufacturing work into funding that goes straight back into product improvement and training.

Sensiba gives you a values-driven, engineering-based approach backed by a top 75 U.S. firm. It brings 200-250 professionals and a long track record across hundreds of annual R&D engagements.
The company’s three-tier model stands out because it lets you dial service levels based on risk tolerance. This includes a basic calculation for low-complexity work, which is a focused payroll-offset study for startups, or a full audit-ready analysis for larger claims. That structure matters when Section 174 forces you to tighten documentation and link project-level work to capitalization schedules.
Lastly, Sensiba’s B Corp certification and multiple Best of Accounting awards give you a sense of consistency.
And when your engineering data feels fragmented, Chrono Platform reduces the heavy lift by giving this company cleaner, categorized project inputs.

Anchin takes a more technical, industry-specialized route. It’s shaped by a 100-year firm with roughly 600 people and deep Research & Development leadership. This broad team redesigns accounting and project systems to capture QREs more accurately. Of course, this can help when your organization struggles with mixed roles, weak hour tracking, or legacy tooling.
The firm’s methodology also gives you flexibility since it compares regular vs. ASC early. Then it builds custom documentation tied to how your teams design, test, and validate features.
That approach becomes clearer when you look at a coconut-water company they helped. This example shows how they map real experimentation into a defendable claim with ion-exchange trials, electrodialysis tests, and supply usage.
For SMEs in manufacturing, software, or life sciences, this systemized technical review matters more than speed. It protects claims under scrutiny and aligns better with long product cycles.

McGuire Sponsel is a strong fit if you care most about audit defense and alignment with your CPA. The firm now partners with more than 450 CPA firms across all 50 states and focuses on documentation that holds up under IRS and state review.
In practice, this team of CPAs, engineers, and enrolled agents runs both retroactive and current-year studies, then stays involved if an examination starts. And the automotive automation case shows the effect. The company identified $4.1 million in qualified research expenses and delivered about $260,000 in federal credits.
That depth helps when Section 174 questions force you to explain methods. And if your internal records are incomplete, fieldwork interviews and project review help close gaps.

KBKG suits you if you want scale, technology, and clear guidance on method choice. Since 1999, this company has unlocked more than $10 billion in tax credits and incentives. It also supports thousands of CPAs and businesses from offices across the U.S.
The firm’s tools estimate benefits at roughly 12-16 cents of credit per qualified dollar, then its specialists refine the numbers and pick between ASC and regular methods.
This is also where Chrono Platform fits well.
When your engineering activity already comes structured from Chrono Platform, KBKG’s team can focus on method, supply rules, and Section 174 strategy instead of cleaning inconsistent time records. That mix works when you want national-firm expertise without forcing your teams into heavy manual tracking just to support a claim.
Finding the right consultant comes down to how well they handle the realities of your engineering workflow rather than how well they summarize the legislation. With that in mind, here are the criteria that matter most when your data, roles, and timelines aren’t clean or linear.
Most SMEs don’t maintain perfect project logs. That’s normal, but not really useful for your goals. The real question is whether a consultant can extract signals correctly from calendars, commits, prototypes, and partial financials.
In most cases, the answer is no.
That’s why 77% of checked R&D claims required adjustments during HMRC reviews, which is a clear sign that documentation gaps are widespread.
So, a capable partner can compensate for those gaps through interviews, sampling methods, and structured reconstruction, reducing the risk of rework later.
Mixed roles can create allocation challenges. This includes engineers shipping production code while prototyping new methods.
A strong consultant knows how to separate eligible research time from delivery work using activity mapping. That precision protects your claim if regulators question boundaries between experimentation and routine engineering.
Manual collection always breaks down under pressure. So, an R&D tax professional who builds automation into their workflow helps you maintain consistent evidence even during tight release cycles.
This structure typically removes substantial overhead. In fact, up to 150+ hours are saved annually when automation replaces ad-hoc tracking. The result is cleaner data and fewer surprises at filing.
Audit defense relies on clear technical narratives, aligned financials, and a consistent methodology. When those pieces don’t line up, even strong R&D work can get challenged. But having a reliable consultant prepares you for those conversations long before a notice arrives.
Your partner should connect wages, contractor costs, and materials directly to R&D workstreams and explain the assumptions behind each allocation. This reduces exposure in a space where the IRS increasingly challenges claims that lack clear documentation.
So, remember that clear mapping keeps your claim defensible and aligned with risk tolerance.
The right R&D tax credit consultant is the one who can work with your real engineering workflow, handle incomplete data, and protect your claim under pressure. The firms that we mentioned here differ in how they manage documentation gaps, interpret blended technical roles, prepare for audits, and map financials to project work.
Some bring deep engineering expertise, while others focus on compliance, process, or scale. Together, these differences shape the reliability of your claim and the effort required from your team.
Now, are you ready to replace manual evidence gathering with automated, audit-ready engineering data and reduce the risk built into traditional consulting workflows?
Then, reach out to Chrono Platform to see how much stronger and simpler your next claim can be.
R&D activity qualifies when a project aims for a scientific or technological advance by resolving uncertainties that a competent professional cannot easily solve. This includes structured experimentation (testing, prototyping, or iterative trials) based on engineering or computer-science principles.
SMEs calculate their credit by identifying qualified research activities and applying the correct enhancement rate. Accuracy depends on linking each cost to a documented technical activity with clear time allocation across blended roles.
With this in mind, Chrono Platform strengthens the process by capturing real-time engineering data from tools like Jira, auto-classifying work with AI, and generating audit-ready narratives that anchor QREs to specific workstreams.
In the U.S., the federal R&D Tax Credit (IRC §41) is not refundable and does not have a dollar-cap specific to SMEs. Qualified small businesses (QSBs) may instead apply up to $250,000 per year of R&D credit against payroll tax if they meet Section 41(e) criteria and have average gross receipts under $5 million and no more than five years of gross receipts.
SMEs should track R&D costs continuously and map them to technical work as they occur. Chrono Platform supports this by syncing engineering data with accounting systems to maintain contemporaneous evidence and produce real-time estimates. Businesses typically book the credit through in-year estimates or true-ups during tax filing.
The SME R&D tax credit gives smaller companies a higher benefit rate because the program focuses on helping businesses with limited resources offset innovation costs. Large companies use the RDEC scheme, which offers a lower benefit rate and shows the credit above the line as taxable income.
Section 174 now allows immediate expensing for domestic R&D from 2025 onward, with small firms able to amend 2022-2024 returns to recover capitalized costs. However, foreign R&D still requires 15-year amortization, which makes geographic tracking important.